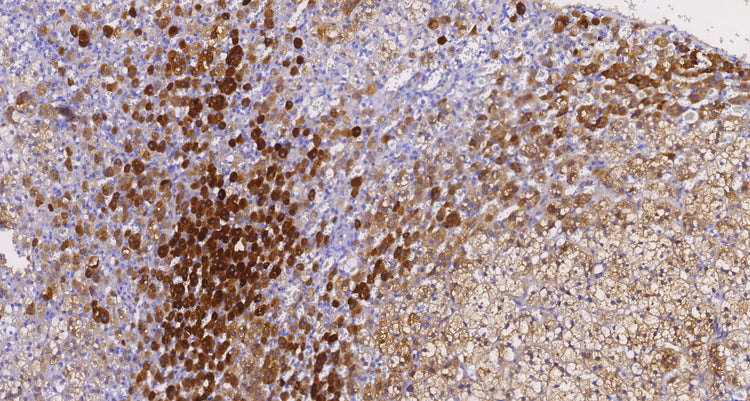

Acerca de
Las inhibinas son hormonas peptídicas producidas por las células de la granulosa en los folículos femeninos y las células de Sertoli en los túbulos seminíferos masculinos. Se expresan principalmente en células de origen estromal del cordón sexual y desempeñan un papel en la regulación de la función de la glándula pituitaria al inhibir la secreción de la hormona folículo estimulante (FSH).
La inhibina está compuesta por una subunidad alfa y una subunidad beta que están unidas por enlaces disulfuro. Hay dos formas de inhibina, que se diferencian en sus subunidades beta (A o B), mientras que sus subunidades alfa siguen siendo las mismas. La inhibina pertenece a la familia de proteínas del factor de crecimiento transformante beta (TGF-beta).
Se ha descubierto que el anticuerpo inhibina alfa es útil para diferenciar entre tumores de la corteza suprarrenal y carcinoma de células renales, dos tipos de tumores que pueden resultar difíciles de distinguir basándose únicamente en sus características histológicas. Además, este anticuerpo ha mostrado positividad citoplasmática en tumores del estroma del cordón sexual del ovario y tumores trofoblásticos.
Las inhibinas son hormonas peptídicas producidas por las células de la granulosa en los folículos femeninos y las células de Sertoli en los túbulos seminíferos masculinos. Se expresan principalmente en células de origen estromal del cordón sexual y desempeñan un papel en la regulación de la función de la glándula pituitaria al inhibir la secreción de la hormona folículo estimulante (FSH).
La inhibina está compuesta por una subunidad alfa y una subunidad beta que están unidas por enlaces disulfuro. Hay dos formas de inhibina, que se diferencian en sus subunidades beta (A o B), mientras que sus subunidades alfa siguen siendo las mismas. La inhibina pertenece a la familia de proteínas del factor de crecimiento transformante beta (TGF-beta).
Se ha descubierto que el anticuerpo inhibina alfa es útil para diferenciar entre tumores de la corteza suprarrenal y carcinoma de células renales, dos tipos de tumores que pueden resultar difíciles de distinguir basándose únicamente en sus características histológicas. Además, este anticuerpo ha mostrado positividad citoplasmática en tumores del estroma del cordón sexual del ovario y tumores trofoblásticos.
Inhibina, alfa (C6H12), MMab
Translation missing: es.products.product.sku:inhibin,-alpha(c6h12),-mmab-0.1ml
No se pudo cargar la disponibilidad de retiro